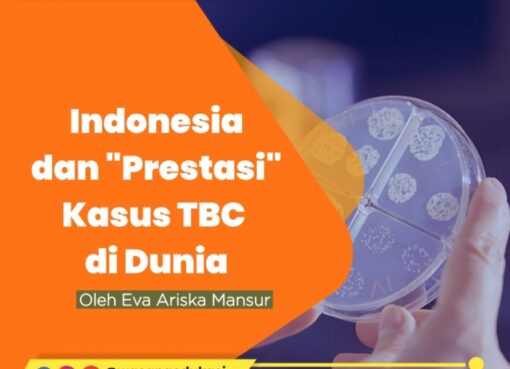

wacana-edukasi.com, SURAT PEMBACA–Pelindungan kekayaan intelektual secara umum mencakup pelindungan yang bersifat makro dan akan berdampak pada pertumbuhan ekonomi nasional suatu negara. Sedangkan secara mikro, kekayaan intelektual diharapkan dapat memenuhi kehidupan ekonomi para inventor dan pencipta.
Berbicara tentang kekayaan intelektual, bukanlah semata-mata mengenai masalah pelindungan hukum, kekayaan intelektual, namun juga erat kaitannya dengan alih teknologi, pembangunan ekonomi dan martabat bangsa
Kekayaan intelektual, lebih lengkapnya adalah hak atas kekayaan intelektual adalah jenis kekayaan yang memuat kreasi tak mewujud dari intelektualitas. HaKI memiliki banyak jenis, dan banyak negara mengakui keberadaannya. Contoh yang paling dikenal adalah Paten, Merek, Desain Industri, Hak Cipta, Indikasi Geografis, Rahasia Dagang dan lain-lain.
Direktorat Jenderal Kekayaan Intelektual (DJKI) bersama Japan International Cooperation Agency (JICA) didukung Kanwil Kemenkumham Kalbar menggelar seminar pelindungan dan pemanfaatan KI bagi kalangan universitas, industri dan usaha kecil menengah di Pontianak, Kalimantan Barat (https://kalbar.prokal.co 13/10/2023).
Kegiatan ini dihadiri Direktur Kerjasama dan Pengembangan Kekayaan Intelektual Sri Lastami, Kepala Divisi Pelayanan Hukum dan HAM Kalbar Eva Gantini, Plh. Kepala Divisi Pemasyarakatan Eka Jaka Riswantara, JICA Expert di DJKI Mr. Oka Hiroyuki, Sekretaris JICA Vera, Interpreter JICA Ms. Urara Numazawa, Kepala Bidang Pelayanan Hukum Muhayan, Kepala Sub Bidang Pelayanan KI Andy Hermawan Prasetio, Penyuluh Hukum Ahli Madya Rini Setiawati dan Sri Ayu Septinawati beserta jajaran dari DJKI maupun Kanwil Kemenkumham Kalbar.
Sebenarnya menjadi tidak tepat akan hadirnya lembaga asing dalam mengangkat Kekayaan Intelektual (KI) dalam Perkembangan perdagangan global di Kalbar, sama saja menghadirkan bahaya bagi Indonesia. Baik dari sisi ekonomi juga dari perspektif sumber daya manusia. Berpotensi menimbulkan permasalahan sebab KI sangat lekat dengan pertumbuhan perekonomian suatu negara. Keduanya tumbuh sejalan. Jika perekonomian tersebut tergantung pada investasi asing, maka pihak asing pun akan sangat berkepentingan untuk ‘mempermainkan’ KI tersebut.
Sebenarnya di dalam Islam tidak ada yang namanya hak cipta. Pemegang Hak Cipta adalah Pencipta sebagai pemilik Hak Cipta, pihak yang menerima hak tersebut secara sah dari Pencipta, atau pihak lain yang menerima lebih lanjut hak dari pihak yang menerima hak tersebut secara sah.
Perlindungan hak cipta adalah idea dan undang-undang yang berasal dari ideologi kapitalisme Barat. Yang tidak layak kita adopsi dan justru yang akan membuat perdagangan kian kacau dan dengan iklim tidak sehat. Karena Islam punya mekanisme sendiri dalam mengatur ekonomi dan perdagangan yang mensejahterakan dan memberi keadilan bagi tiap kalangan. Wallahua’lam.
Yeni
Pontianak, Kalbar
Views: 2

Comment here